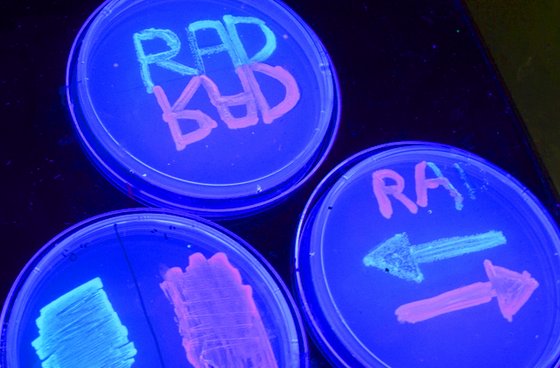
Αποθήκευση δεδομένων στο DNA ζωντανών κυττάρων πέτυχαν Αμερικανοί επιστήμονες

Άρειος Πάγος: Έκδοση του «βασιλιά» του Bitcoin στις ΗΠΑ
Την έκδοση στις ΗΠΑ του 38χρονου Αλεξάντρερ Βίνικ, του αποκαλούμενου βασιλιά του bit coin πρότεινε η εισαγγελέας του ποινικού Τμήματος του Αρείου Πάγου. Ο κατηγορούμενος εξήγησε στην απολογία του τους λόγους που δεν θέλει να εκδοθεί στις ΗΠΑ ενώ έχει συναινέσει ήδη να εκδοθεί στη Ρωσία για μια μικροαπάτη 10.000 ευρω. Όπως ισχυρίστηκε δεν έχει διαπράξει το αδίκημα για το οποίο ζητείται η έκδοσή του εν διατύπωσε και φόβους ότι στις ΗΠΑ δεν θα έχει μία δίκαιη δίκη.

Αριθμός Πιστοποίησης Μ.Η.Τ.232442
Αριθμός Πιστοποίησης Μ.Η.Τ.232442